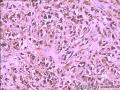

| 图片: | |
|---|---|
| 名称: | |
| 描述: | |
- 好奇怪的淋巴结,求教
| 性别 | 男 | 年龄 | 30 | 临床诊断 | |
|---|---|---|---|---|---|
| 一般病史 | 男性,30岁。因腹痛、腹胀伴乏力、呕吐、腹泻1+月入院。 查体:体温波动在37-39℃,肝脾肋下触及不满意,移浊(-),余未见明显异常。CT 示:腹膜后淋巴结广泛肿大。血常规:WBC;9.1×109/L,RBC;2.2×1012/L,PLT;190×109/L。 | ||||
| 标本名称 | 淋巴结 | ||||
| 大体所见 | 骨髓涂片:有核细胞增生明显活跃,粒红比1.8∶1,减低,粒系统尚可,各阶段细胞偏大,成熟红细胞大小不均,以小细胞为主,淋巴细胞形态正常,意见:感染性骨髓。 大体发现:腹腔淋巴结灰红淡黄结节,1cm×1cm×0.5cm,切面灰白。 | ||||
标签:淋巴结
-
本帖最后由 westchina 于 2013-07-22 18:59:12 编辑
×参考诊断